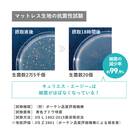
シングルマットレス(LT9900 PW ハード)【島忠ホームズ商品】 4枚目画像

ニトリ
シングルマットレス(LT9900 PW ハード)【島忠ホームズ商品】
商品コード
2100002421129
仕様・サイズ



| サイズ | 幅97×奥行195×高さ28cm |
| 素材 | 高密度連続スプリング |
| 重量 | 約26kg |
| 保証年数 | 5年 |
| 組立時間 | 0分 |
| カラー | グレー |
| 梱包サイズ | 幅97×奥行195×高さ28cm |
商品説明
●抜群の通気性と反発力で優しく支えて、しなやかに眠りをサポートします。
●両面にブレスエアーエクストラを採用。
●端まで強いプロ・ウォール仕様
マットレスの端を強化し、有効面積を広げワンランク上の寝心地を実現。
ベッドからも楽に立ち上がれます。
●防ダ二、抗菌、防臭。
●銀イオンによる除菌機能キュリエス・エージー。
銀イオンの力でいつも清潔に保ちます。
●環境配慮型マットレス解体システムモアリ―仕様。
解体、分別が容易な構造で、リサイクルしやすいマットレス解体システムモアリ―を採用することで、環境保全に貢献しています。
●高通気で中まできれいな高密度連続スプリング。
1本の鋼線を緻密に編み上げる高度な製法により、継ぎ目のない一体化した中空構造を実現することで、内側に湿気をためない構造です。
●保湿性と保温性に優れた羊毛入りです。
●生地のソフト感を最大限に引き出すジャンプキルト。
●安心の日本製です。

【島忠店舗商品コード】
●4954281679485
●両面にブレスエアーエクストラを採用。
●端まで強いプロ・ウォール仕様
マットレスの端を強化し、有効面積を広げワンランク上の寝心地を実現。
ベッドからも楽に立ち上がれます。
●防ダ二、抗菌、防臭。
●銀イオンによる除菌機能キュリエス・エージー。
銀イオンの力でいつも清潔に保ちます。
●環境配慮型マットレス解体システムモアリ―仕様。
解体、分別が容易な構造で、リサイクルしやすいマットレス解体システムモアリ―を採用することで、環境保全に貢献しています。
●高通気で中まできれいな高密度連続スプリング。
1本の鋼線を緻密に編み上げる高度な製法により、継ぎ目のない一体化した中空構造を実現することで、内側に湿気をためない構造です。
●保湿性と保温性に優れた羊毛入りです。
●生地のソフト感を最大限に引き出すジャンプキルト。
●安心の日本製です。

【島忠店舗商品コード】
●4954281679485